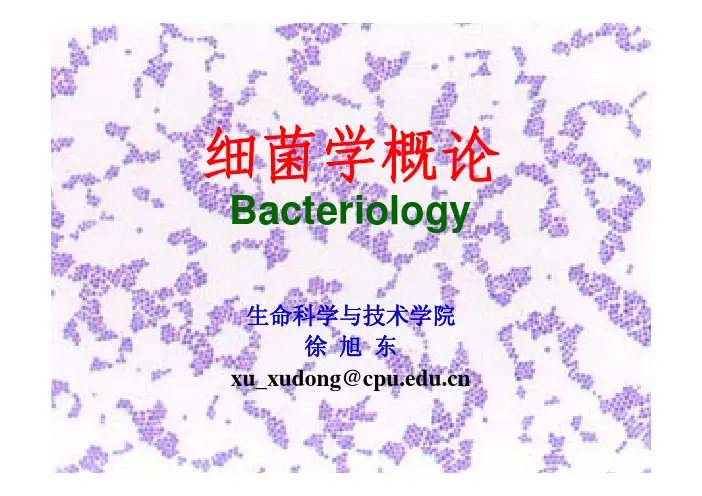

细菌的基本结构3
- 格式:ppt
- 大小:12.04 MB
- 文档页数:110

项目二细菌任务一细菌的形态结构一、细菌的形态结构(一)细菌细胞的形态和排列方式细菌细胞的基本形态有球状、杆状、螺旋状三种(图1-1),分别称为球菌、杆菌和螺旋菌,其中以杆状最为常见,球状次之,螺旋状较为少见。
仅有少数细菌或一些细菌在培养不正常时为其他形状,如丝状、三角形、方形、星形等。
图1-1 细菌的三种基本形态(左为模式图,右为照片)1. 球菌球菌单独存在时,细胞呈球形或近球形。
根据其繁殖时细胞分裂面的方向不同,以及分裂后菌体之间相互粘连的松紧程度和组合状态,可形成若干不同的排列方式(图1-2)。
A B C DE F图1-2 球菌的形态及排列方式(A.单球菌; B.双球菌; C.四联球菌; D.八叠球菌; E.链球菌; F 葡萄球菌)(1)单球菌细胞沿一个平面进行分裂,子细胞分散而独立存在,如尿素微球菌。
(2)双球菌细胞沿一个平面分裂,子细胞成双排列,如褐色固氮菌。
(3)四联球菌细胞按两个互相垂直的平面分裂,子细胞呈田字形排列,如四联微球菌。
(4)八叠球菌细胞按三个互相垂直的平面分裂,子细胞呈立方体排列,如尿素八叠球菌。
(5)链球菌细胞沿一个平面分裂,子细胞成链状排列,如溶血链球菌。
(6)葡萄球菌细胞分裂无定向,子细胞呈葡萄状排列,如金黄色葡萄球菌。
细菌细胞的形态与排列方式在细菌的分类鉴定上具有重要的意义。
但某种细菌的细胞不一定全部都按照特定的排列方式存在,只是特征性的排列方式占优势。
2. 杆菌杆菌细胞呈杆状或圆柱状,形态多样。
不同杆菌其长短、粗细差别较大,有短杆或球杆状(长宽非常接近),如甲烷短杆菌属;有长杆或棒杆状(长宽相差较大),如枯草芽孢杆菌。
不同杆菌的端部形态各异,有的两端钝圆,如腊状芽孢杆菌;有的两端平截,如炭疽芽孢杆菌;有的两端稍尖,如梭菌属;有的一端分支,呈“丫”或叉状,如双歧杆菌属,有的一端有一柄,如柄细菌属。
也有的杆菌稍弯曲而呈月亮状或弧状,如脱硫弧菌属。
杆菌的细胞排列方式有“八”字状、栅状、链状等多种(图1-3)。


初中生物细菌知识点归纳总结细菌是生物学中的一个重要组成部分,对于初中生来说,了解细菌的基本特性、生存环境、分类以及与人类的关系是非常必要的。
以下是对初中生物课程中细菌知识点的归纳总结。
一、细菌的基本特性1. 形态:细菌的形态多样,包括球形、杆形、螺旋形等。
2. 细胞结构:细菌具有细胞壁、细胞膜、胞质和核糖体等基本结构,但没有成形的细胞核。
3. 大小:细菌的体积微小,一般在1-10微米之间,需用显微镜才能观察到。
4. 繁殖方式:细菌主要通过二分裂方式进行繁殖,繁殖速度快。
二、细菌的生存环境1. 营养需求:细菌需要水分、碳源、氮源、矿物质和维生素等营养物质。
2. 温度:细菌的生存温度范围广泛,有的细菌在低温下生存,如冷藏食品中的细菌;有的则在高温下生存,如热水中的嗜热菌。
3. 氧气:根据对氧气的需求,细菌可分为需氧菌、厌氧菌和兼性厌氧菌。
三、细菌的分类1. 根据形态分类:球菌、杆菌、螺旋菌。
2. 根据生存环境分类:土壤细菌、水生细菌、寄生细菌等。
3. 根据氧气需求分类:需氧细菌、厌氧细菌、兼性厌氧细菌。
四、细菌与人类的关系1. 有益细菌:部分细菌对人类有益,如乳酸菌可用于制作酸奶、泡菜等发酵食品。
2. 致病菌:有些细菌能引起疾病,如肺炎链球菌、大肠杆菌等。
3. 细菌与环境保护:细菌在自然界物质循环中起着重要作用,如分解有机物、净化污水等。
五、细菌的控制与利用1. 控制细菌繁殖:通过高温、紫外线、化学消毒剂等方法可以杀死或抑制细菌的繁殖。
2. 细菌的应用:在食品工业、医药制造、生物工程等领域,细菌的利用十分广泛。
六、细菌的实验室培养1. 培养基的制备:选择合适的培养基,如营养琼脂,为细菌提供适宜的生长环境。
2. 接种与培养:将细菌接种到培养基上,并在恒温箱中进行培养。
3. 观察与记录:定期观察细菌的生长情况,并记录相关数据。
七、细菌的防治1. 个人卫生:勤洗手、保持食物清洁等个人卫生习惯可以有效预防细菌感染。
细菌学概论Bacteriology生命科学与技术学院徐旭东xu_xudong@第一节细菌的形态、结构与分类一、细菌的大小和形态(一)细菌的大小细菌的测量单位为微米(μm),一般球菌直径平均大小为1.0μm,杆菌为1~5 μm×0.5~1.0 μm。
(二)细菌的形态细菌的基本形态有球菌、杆菌和螺形菌三种;1. 球菌(coccus, cocci):双球菌、链球菌、葡萄球菌;2. 杆菌(bacillus, bacilli):长杆菌、短杆菌;3. 螺形菌(spirilla):弧菌(vibrio)、螺菌(spirillum)。
金黄色葡萄球菌(Staphylococcus aureus,电镜)常见细菌形态常见细菌形态大肠杆菌(Escherichia coli,电镜)大肠杆菌和枯草杆菌(Bacillus subtilis)常见细菌形态拟态弧菌(vibrio mimicus,电镜)常见细菌形态霍乱弧菌(Vibriocholerae)常见细菌形态幽门螺杆菌(Helicobacter pylori)常见细菌形态各种细菌的形态和排列链球菌Coccoid-shaped Bacterium, Streptococcus faecalis(SEM×33,370).This image is copyright Dennis Kunkel藤黄八叠球菌(Sarcina leteus,电镜)四联微球菌(Micrococcus tetragenus,电镜)(三)细菌的特殊形态除上述基本形态的细菌之外,还有一些特殊形态的细菌,如长有附属丝的红微菌,丝状的亮发菌等。
其他还有梨状、盘碟状、方形、三角形等。
红微菌的形态右:模式图,左:显微照片亮发菌的形态方形细菌(square-shaped bacteria)星形细菌(star-shaped bacteria)(一)细菌细胞的基本结构1. 细胞壁(cell wall)细胞壁主要是由肽聚糖(peptidoglycan)组成,又称粘肽(mucopeptide);肽聚糖由N-乙酰葡萄糖胺(N-acetylglucosamine,G)、N-乙酰胞壁酸(N-acetylmuramic acid,M)和短肽侧链组成;G和M交替排列,通过β-1,4糖苷键连接成长链骨架;短肽侧链将长链骨架连接成空间网格状结构。


细菌细胞壁的结构组成细菌是一类微小的单细胞生物,广泛存在于自然界中。
细菌细胞壁是细菌细胞的外部保护层,它不仅能提供细胞形状和结构的支持,还能保护细胞免受外界环境的侵害。
细菌细胞壁的结构组成与其功能密切相关,下面将详细介绍细菌细胞壁的组成和特点。
1. 基本结构细菌细胞壁主要由两个主要成分组成:胞壁多糖和胞壁蛋白。
胞壁多糖是细菌细胞壁的主要组分,包括肽聚糖和多聚糖。
肽聚糖是由N-乙酰葡萄糖胺和N-乙酰葡萄糖组成的聚糖链,通过肽链相互连接起来。
多聚糖是由N-乙酰葡萄糖和N-乙酰甘露糖组成的聚糖链,通过β-1,4-糖苷键连接起来。
胞壁蛋白则是通过共价键与胞壁多糖结合在一起,形成细菌细胞壁的网状结构。
2. 不同细菌的细胞壁结构细菌细胞壁的结构在不同的细菌中存在差异。
根据细菌细胞壁的特点,可以将细菌分为两类:革兰氏阳性细菌和革兰氏阴性细菌。
革兰氏阳性细菌的细胞壁结构相对简单。
其细胞壁主要由肽聚糖和多聚糖组成,肽聚糖链与多聚糖链交错排列形成网状结构。
此外,革兰氏阳性细菌的细胞壁中还含有大量的胞壁蛋白。
这种细胞壁结构使得革兰氏阳性细菌在革兰染色中会呈现紫色。
相比之下,革兰氏阴性细菌的细胞壁结构更加复杂。
革兰氏阴性细菌的细胞壁由内膜、外膜和中间的边缘层组成。
内膜是细菌细胞内部的脂质双层,外膜则是细菌细胞壁的外层保护层。
中间的边缘层主要由肽聚糖和多聚糖组成。
由于外膜的存在,革兰氏阴性细菌在革兰染色中会呈现红色。
3. 细菌细胞壁的功能细菌细胞壁具有多种重要功能。
细菌细胞壁能够提供细胞形状和结构的支持。
细菌细胞壁的网状结构能够保持细胞的形态稳定,使细菌能够适应不同的环境。
细菌细胞壁能够保护细胞内部免受外界环境的侵害。
细菌细胞壁的多聚糖和肽聚糖能够形成一个密实的屏障,阻止有害物质进入细胞。
细菌细胞壁还能够参与细菌的营养吸收和代谢过程。
细菌细胞壁上的一些蛋白质可以与外界环境中的营养物质结合,促进细菌的吸收和利用。
4. 细菌细胞壁与抗生素的关系细菌细胞壁的结构和功能对抗生素的作用具有重要影响。

简述细菌的基本结构和特殊结构
细菌是一类单细胞的微生物,其基本结构主要包括细胞壁、细胞膜、细胞质、核酸和一些附属结构。
1. 细胞壁:细菌的细胞壁是由多糖、蛋白质和其他化合物构成的,可以提供细胞形态的支持和保护细菌免受外界环境的损害。
根据细菌细胞壁的不同组成,可以将细菌分为两类:革兰氏阳性菌和革兰氏阴性菌。
2. 细胞膜:细菌的细胞膜包裹细胞质,起着维持细菌内外环境平衡的作用,同时也是许多代谢反应和物质运输的场所。
3. 细胞质:细菌的细胞质是由水、溶质、蛋白质、核酸等组成的胶状物质,其中包含细菌的代谢酶、核糖体等重要的细胞器。
4. 核酸:细菌的遗传物质主要是DNA(脱氧核糖核酸),位于细菌的核区内,控制着细菌的生长、繁殖和代谢。
此外,细菌还可以具有一些特殊的结构,例如:
1. 胞外多聚物:细菌表面可能存在胞外多聚物,如胞外多糖和胞外蛋白质,它们可以提供细菌的附着能力、保护作用和抵抗宿主免疫系统的攻击。
2. 鞭毛:有些细菌表面具有鞭毛,它们可以帮助细菌在液体中游动或附着在宿主细胞表面。
3. 菌毛:菌毛是一种细菌表面的纤毛状结构,可以帮助细菌与宿主细胞结合或在宿主细胞表面形成结构复杂的生物膜。
4. 质粒:质粒是一种存在于细菌细胞质中的小环状DNA分子,
它们可以携带和传递一些额外的遗传信息,如抗药性基因和代谢途径相关基因。
细菌的基本结构和特殊结构的存在使得它们能够适应不同的生存环境,并发挥重要的生态和生理功能。


细菌的特殊结构及功能
1. 细菌的基本结构
细菌是微生物中最简单的一类,通常呈现出单细胞的形态。
细菌的基本结构包括:•细胞壁:由蛋白质和多糖组成,提供细菌的结构支持和保护。
•细胞膜:控制物质进出细菌细胞的关口。
•核区:含有细菌的遗传物质DNA。
•质粒:可在细菌间传递的额外DNA片段。
•细胞器:如核糖体、线粒体等。
2. 细菌的功能
细菌的特殊结构赋予它们多种功能:
•光合作用:某些细菌能够进行光合作用,利用光能合成有机物质。
•异养作用:有些细菌以其他有机物质为碳源,进行异养作用。
•分解作用:许多细菌能分解有机物质,起到腐解和分解的作用。
•共生作用:某些细菌与其他生物形成共生关系,相互受益。
•产生抗生素:部分细菌具有产生抗生素的能力,对疾病治疗有重要作用。
•生物修复:特定细菌可以帮助修复环境中的污染物。
3. 细菌的分类
根据细菌的形态、生理特征和遗传特征,可以将其分为多个类别:
1.按形态分类:球菌、杆菌、弧菌等。
2.按需氧性分类:需氧菌、厌氧菌、嗜氧菌等。
3.按染色性分类:革兰氏阳性菌、革兰氏阴性菌。
4.按代谢分类:光合细菌、化能细菌等。
4. 细菌在生活中的作用
细菌在生活中具有重要的作用:
•食品工业:发酵过程中的细菌可制造乳酸、酒精等。
•环境清洁:某些细菌可以分解污水和有机废物,帮助环境清洁。
•医学应用:细菌在疾病诊断、药物研发等方面发挥重要作用。
•农业领域:某些细菌能够促进植物生长,提高农作物产量。
•生态平衡:细菌在自然界中起到维持生态平衡的作用。

细菌的形态与结构考点总结细菌是一类具有细胞壁的单细胞原核细胞型微生物,体积微小,结构简单,无典型的细胞核(无核膜和核仁),无内质网、高尔基复合体等细胞器,具有细胞壁,不进行有丝分裂。
在适宜的培养条件下,细菌有相对恒定的形态与结构,经过适当的染色处理,可用光学显微镜或电子显微镜观察与识别。
一、细菌的大小和形态大小:形体微小,通常以微米作为测量单位。
形态:◇球菌◇双球菌;链球菌;葡萄球菌;四联球菌和八叠球菌。
◇杆菌◇螺形菌◇弧菌;螺菌。
影响细菌形态的因素:①培养条件;②机体内生态环境;③环境中不利于细菌生长的物质。
二、细菌的结构(一)基本结构1.细胞壁细胞壁是包被于细菌细胞最外层具有坚韧性和弹性的复杂结构。
细胞壁的主要功能:①维持菌体固有形态并起保护作用。
②与细胞膜共同完成菌体内外的物质交换。
③细胞壁上的抗原决定簇,决定着菌体的抗原性。
④细胞壁是鞭毛运动的支点。
◇革兰阳性菌(G+菌)◇革兰阴性菌(G-菌)化学组成◇基本成分:肽聚糖◇G+菌特有成分:磷壁酸◇G-菌特有成分:外膜。
位于细胞壁肽聚糖的外侧,由脂多糖、脂质双层(磷脂)、脂蛋白三部分组成。
革兰氏阳性细菌革兰氏阴性细菌革兰阳性菌与革兰阴性菌细胞壁结构比较结构革兰阳性菌革兰阴性菌肽聚糖组成聚糖骨架、四肽侧链、五肽交联桥聚糖骨架、四肽侧链层数可达50层仅1~2层含量占细胞壁干重的50%~80% 占细胞壁干重的5%~10% 机械强度强,较坚韧差,较疏松磷壁酸有无外膜无有周浆间隙无有2.细胞膜(1)细胞膜的结构和成分结构——脂质双层化学成分——脂质、蛋白质、少量多糖(2)细胞膜的主要功能①物质转运②生物合成③呼吸作用④分泌作用中介体:又称中间体,是细胞膜内陷折叠而成的管状、囊状结构。
其功能类似真核细胞的线粒体,故有人称之为类线粒体。
3.细胞质(1)核糖体:蛋白质的合成场所。
(2)核质:一条细长的闭环双链DNA反复盘绕卷曲而成的块状物。
核质决定细菌性状和遗传特征,是细菌的主要遗传物质。
